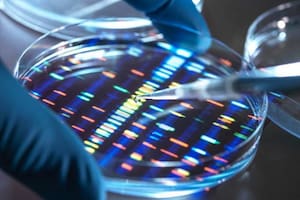
Desafían las leyes de la física y prometen solucionar el problema del almacenamiento masivo de datos

Viruela del mono: 5 preguntas sobre la enfermedad que causa alerta a nivel mundial
Se trata de un virus que se descubrió por primera vez en el año 1958; cuáles son los riesgos que presenta , cómo se contagia, cuáles son sus síntomas
 4 minutos de lectura'
4 minutos de lectura'

Una rara infección se identificó entre los habitantes del Reino Unido, España y Portugal, y se disparó una alarma mundial. Se trata de la viruela del mono, un virus que se propaga tanto en humanos como en animales y que es potencialmente mortal. Ya hay más de 7 pacientes confirmados y varios casos sospechosos, por lo que se teme que haya transmisión comunitaria.
En este contexto, la Organización Mundial de la Salud (OMS) busca esclarecer las respuestas que abren paso a una nueva preocupación entre la población mundial.
Qué es la viruela del mono
La viruela del mono es causada por el virus ortopoxvirus, similar al virus Variola, causante de la viruela, una enfermedad que se erradicó el 8 de mayo de 1980. Su área de influencia suelen ser las zonas de África Occidental y Central. Cabe mencionar que la enfermedad se descubrió por primera vez en 1958, cuando se registraron dos brotes en colonias de monos utilizados para una investigación. De ahí surge el nombre de “viruela del mono” o “viruela símica”.
El primer caso humano de esta extraña infección se notificó en 1970 en Bokenda, una aldea ubicada en la República Democrática del Congo. Se trató de un bebé de 9 meses que ingresó al Hospital Basankusu con síntomas similares a los de la viruela, que se caracteriza por provocar fiebre y por la aparición de ampollas de pus en la piel. No obstante, una muestra enviada al Centro de Referencia de Viruela de la OMS en Moscú reveló que los síntomas del niño en realidad eran causados por el virus de la viruela del mono.
Cuáles son los síntomas de la viruela del mono
Si bien esta enfermedad suele ser poco contagiosa entre los humanos, hay diversos síntomas que los pacientes confirmados presentan: fiebre, dolor de cabeza, dolores musculares, dolor de espalda, ganglios linfáticos inflamados, escalofríos y fatiga.
Además, pueden aparecer sarpullidos, generalmente en la cara, que luego se extiende a otras partes del cuerpo, como las palmas de las manos y las plantas de los pies. La irritación de la piel genera una comezón extrema y finalmente se forma una corteza que más tarde se cae.
Aunque la mayoría de los síntomas son leves, esta infección también tiene la capacidad de desarrollarse de forma más severa.
Cómo se transmite la viruela del mono
Según la OMS, la enfermedad suele durar de 2 a 4 semanas. Se cree que la transmisión se produce a través de la saliva o por contacto directo con el exudado (líquido) de la lesión.
Cabe mencionar que la viruela del mono, además de infectar a humanos y primates, también puede hacerlo con roedores como ardillas, ratones y otras especies similares.
Cuántos casos de viruela del mono se contabilizaron en el mes de mayo
Entre el 6 y 14 de mayo de 2022, la Agencia de Seguridad Sanitaria de Reino Unido detectó 4 casos de viruela del mono: 3 en Londres y 1 en el noreste de Inglaterra. “Los cuatro casos se identifican a sí mismos como homosexuales, bisexuales u hombres que tienen sexo con hombres”, detalló en un comunicado en relación a los pacientes confirmados.
Por su parte, Portugal registró más de 20 casos sospechosos y confirmó un total de cinco en la región de Lisboa, mientras que según el Ministerio de Sanidad español difundió una alerta sanitaria por contar 23 casos sospechosos en Madrid, la capital de España.

Cuáles son las recomendaciones para evitar contraer la viruela del mono
Según detalla la OMS en su página web, no hay un tratamiento o vacunas específicas contra la infección del virus. Sin embargo, se pueden controlar los brotes con medidas de precaución básicas:
- Evitar cualquier contacto con roedores y primates, además de limitar la exposición directa a la carne y sangre (consumirlos como alimento).
- Es importante también evitar el contacto físico estrecho con las personas que ya están infectadas, y para visitar a los pacientes se debe usar medidas de seguridad como guantes y un equipo especial, además de mantener una buena higiene de manos antes y después de asistirlos.
 1
1Nuevas investigaciones apuntan a EE.UU. por el ataque a una escuela iraní en el primer día de la guerra
- 2
Trump aseguró que Australia otorgará asilo a algunas jugadoras de la selección de fútbol iraní
- 3
La elección del hijo de Khamenei como nuevo líder supremo de Irán parece cerrar el camino a un rápido fin de la guerra
 4
4Qué dice el mensaje que le envió Vladimir Putin al nuevo ayatollah de Irán